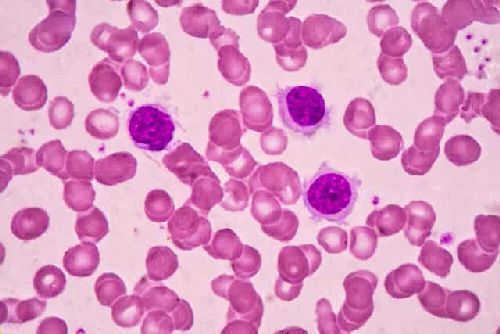

Czy wiesz, czym jest szpiczak mnogi? Poznaj bliżej tę chorobę!

Szpiczak mnogi jest chorobą onkologiczną; innymi słowy, to nowotwór. Jego źródłem jest szpik kostny, który jest tkanką tworzącą komórki krwi. Później będą krążyć one po całym ciele.
Szpik kostny znajduje się wewnątrz kości ciała. Stamtąd właśnie pochodzą komórki, które są przenoszone do tkanki krwi. Wśród tych nich jedną z odmian są komórki plazmatyczne. Są to winowajcy szpiczaka mnogiego, który ogólnie polega na nieprawidłowym rozmnażaniu się tych komórek w nadmiernych ilościach.
W normalnych warunkach komórki plazmatyczne pełnią funkcję zwalczania infekcji. Realizują to zadanie poprzez produkcję substancji zwanych przeciwciałami. Przeciwciała rozpoznają czynniki zakaźne, które próbują wywołać chorobę u ludzi i atakują je.
Szpiczak mnogi to sytuacja, w której w organizmie występuje nieprawidłowy poziom komórek plazmatycznych, co z kolei powoduje zaburzoną produkcję przeciwciał. W efekcie nie uzyskujemy lepszej odporności.. Dzieje się wręcz przeciwnie, taka sytuacja sprzyja infekcjom i wynikającym z nich komplikacjom.
Szpiczak mnogi: czynniki podwyższonego ryzyka
Istnieje wiele czynników, które zwiększają prawdopodobieństwo rozwoju szpiczaka mnogiego. Wśród nich możemy wymienić:
- Wiek: im jesteś starszy, tym większa szansa na zachorowanie na raka, chociaż najbardziej dotknięte tą chorobą są osoby w wieku powyżej sześćdziesięciu pięciu lat.
- Historia występowania szpiczaka mnogiego w rodzinie: istnieją rodziny z pewną predyspozycją do tej Nie jest to czynnik decydujący, ale posiadanie rodzica lub rodzeństwa z chorobą zwiększa ryzyko zachorowania na nią.
- Bycie mężczyzną: mężczyźni cechują się większą częstością występowania tego nowotworu niż kobiety.
- Pochodzenie afroamerykańskie: Afroamerykanie są grupą o wyższym ryzyku zachorowania na szpiczaka mnogiego niż reszta populacji.
Podsumowując, szpiczak mnogi jest nowotworem krwi, drugim najczęściej występującym nowotworem tego typu.
Objawy tego nowotworu
Czasami rozpoznanie szpiczaka mnogiego może być opóźnione z powodu niespecyficznych objawów. Jednakże jest to choroba, w której większość objawów może być mylona z innymi chorobami.
Jeśli lekarz nie ma wyraźnego podejrzenia lub nie wykryje czegoś niezwykłego stosując metody uzupełniające, istnieje ryzyko opóźnienia w wystawieniu właściwej diagnozy.
Wśród najczęstszych objawów możemy wymienić następujące:
- Ból kości: głównie tułowia, klatki piersiowej i pleców.
- Zmiany żołądkowo-jelitowe: obejmuje to wymioty i zaparcia.
- Brak apetytu: brak uczucia głodu, jeśli utrzymuje się on przez dłuższy czas, może doprowadzić do utraty wagi.
- Powtarzające się infekcje: osłabiony układ odpornościowy, jak już wyjaśniono, sprzyja wnikaniu mikroorganizmów, które generują infekcje. Te mikroorganizmy mogą powodować powszechnie spotykane infekcje, które nie ustępują zbyt łatwo.
Zapewne zaciekawi Cię także nasz inny artykuł: 6 nawyków wzmacniających układ odpornościowy
Jak zdiagnozować szpiczaka mnogiego?
Pierwszym krokiem w diagnozowaniu szpiczaka mnogiego jest podejrzenie jego występowania. Jest to bardzo trudne ze względu na niespecyficzne objawy choroby. Z drugiej strony wyniki badania laboratoryjnego zleconego z innego powodu mogą nakierować podejrzenia lekarza na właściwy tor.
Badanem laboratoryjnym, którego celem jest konkretnie szpiczak mnogi, jest poszukiwanie przeciwciał monoklonalnych. Jest to nieprawidłowy rodzaj białka, które zostało nazwane białkiem M. Jeśli się ono pojawi, wskazuje na obecność szpiczaka mnogiego.
Drugim etapem procesu diagnostycznego jest biopsja szpiku kostnego. Wiąże się to z pobraniem części szpiku kostnego i wyodrębnieniem go z wnętrza kości w celu zbadania tej tkanki pod mikroskopem. Dzięki temu można dokładnie obserwować stan komórek plazmatycznych.
Pobrana próbka jest również zwykle poddawana następującym testom:
- Cytogenetyka: jest to analiza DNA pobranych komórek.
- Immunohistochemia: czyli odróżnianie normalnych komórek od nieprawidłowych.
- Cytometria przepływowa: ma ona na celu ustalenie, czy nieprawidłowe komórki są wywołane przez szpiczaka mnogiego lub inny nowotwór krwi, taki jak chłoniak.
Ostateczną diagnozę szpiczaka mnogiego uzyskuje się poprzez biopsję szpiku kostnego.
Leczenie szpiczaka mnogiego
Leczenie szpiczaka mnogiego wymaga wielodyscyplinarnego podejścia z udziałem różnych specjalistów. Zespół onkologiczny zajmujący się tymi pacjentami obejmuje hematologów z doświadczeniem w tej chorobie onkologicznej.

Radioterapia jest jedną z opcji terapeutycznych. Szpiczak mnogi jest wrażliwy na promieniowanie medyczne, które może zmniejszyć zasięg choroby, a także kontrolować ból kości przez nią wywołany.
Chemioterapia jest wskazana u osób, u których doszło do progresji szpiczaka mnogiego. Niestety wskaźniki przeżycia są niskie u pacjentów poddawanych chemioterapii. Szacuje się, że po ponad pięciu latach przeżywa mniej niż jedna trzecia pacjentów.
I na koniec, leczeniem, które jest bardzo skuteczne i ma wiele badań naukowych na poparcie tego, jest przeszczep. W takim przypadku lekarze wykonują autotransplantację szpiku kostnego.
Być może uznasz także ten artykuł za interesujący: Przeszczep komórek macierzystych lekiem na HIV!
Szpiczak mnogi – podsumowanie
Szpiczak mnogi to poważna choroba. Podobnie jak wszystkie inne nowotwory, wymaga szybkiej diagnozy, aby zwiększyć szanse na przeżycie. Jeśli więc masz objawy, które sprawiają, że podejrzewasz u siebie szpiczaka lub masz historię jego występowania w najbliższej rodzinie, najlepiej będzie skonsultować się z lekarzem, by wyjaśnić wszelkie wątpliwości.
Podsumowując, w obliczu jakichkolwiek podejrzeń lekarze mogą pokierować procesem diagnostycznym w celu wykonania niezbędnych badań. W razie potrzeby mogą zamówić najlepsze dostępne leczenie, które jest stale rozwijane i weryfikowane.
Pamiętaj, że rutynowe badania kontrolne są również pomocne w tego typu diagnozach.
Wszystkie cytowane źródła zostały gruntownie przeanalizowane przez nasz zespół w celu zapewnienia ich jakości, wiarygodności, aktualności i ważności. Bibliografia tego artykułu została uznana za wiarygodną i dokładną pod względem naukowym lub akademickim.
- García-Sanz, Ramón, María Victoria Mateos, and Jesús Fernando San Miguel. “Mieloma múltiple.” Medicina Clínica 129.3 (2007): 104-115.
- Díaz-Maqueo, José C. “Historia del mieloma múltiple.” Revista Biomédica 17.3 (2006): 225-229.
- Charlot-Lambrecht, I., et al. “Mieloma múltiple.” EMC-Aparato locomotor 45.1 (2012): 1-13.
Ten tekst jest oferowany wyłącznie w celach informacyjnych i nie zastępuje konsultacji z profesjonalistą. W przypadku wątpliwości skonsultuj się ze swoim specjalistą.







